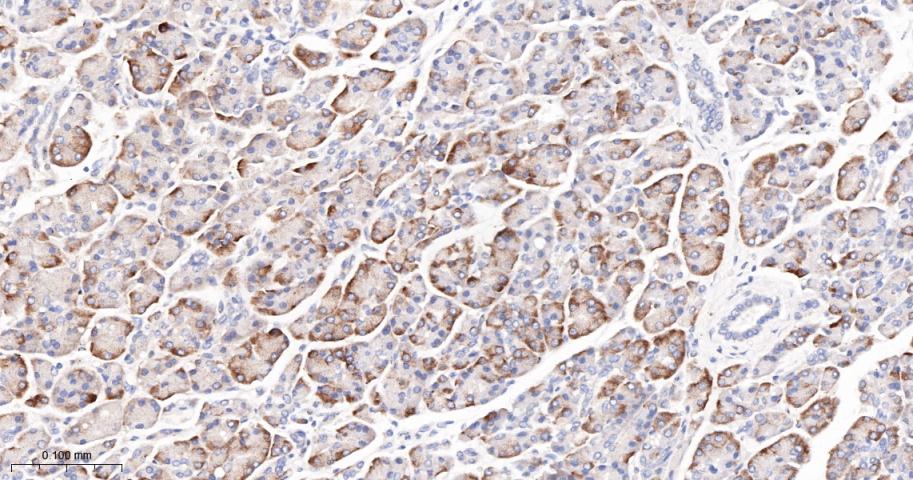
phospho-FoxO3a (Ser253) Recomb

相关产品推荐更多 >

CHRM4 Rabbit pAb(bs-11998R)-50ul/100ul/200ul
¥1180
phospho-MARK1 (Thr215) Rabbit pAb(bs-18680R)-50ul/100ul/200ul
¥1180
Collagen IV Rabbit pAb, BF680 conjugated(bs-4595R-BF680)-100ul
¥2980
ATAT1 Rabbit pAb, Biotin conjugated(bs-9535R-Bio)-100ul
¥2980
NEUROD1 Rabbit pAb, PE conjugated(bs-1517R-PE)-100ul
¥2980
万千商家帮你免费找货
0 人在求购买到急需产品
- 详细信息
- 文献和实验
- 技术资料
- 应用范围:
产品信息以Bioss网站为准
- 规格:
50ul/100ul
| 规格: | 50ul | 产品价格: | ¥1400.0 |
|---|---|---|---|
| 规格: | 100ul | 产品价格: | ¥2500.0 |
| 产品编号 | bsm-52156R |
| 英文名称 | phospho-FoxO3a (Ser253) Recombinant Rabbit mAb |
| 中文名称 | 磷酸化叉头蛋白3A重组兔单抗 |
| 英文别名 | FOXO3a(S253); FOXO3A(phospho S253); p=FOXO3A(phospho S253); FOXO1A(phospho S253); p-FOXO1A(phospho S253); AF6q21; AF6q21 protein; DKFZp781A0677; FKHR2; FKHRL 1; FKHRL1; FKHRL1P2; Forkhead(Drosophila) homolog(rhabdomyosarcoma) like 1; Forkhead box O3; Forkhead box O3A; Forkhead box protein O3; Forkhead box protein O3A; Forkhead Drosophila homolog of in rhabdomyosarcoma like 1; Forkhead homolog(rhabdomyosarcoma) like 1; Forkhead in rhabdomyosarcoma like 1; Forkhead in rhabdomyosarcoma-like 1; FOX O3A; FOXO2; foxo3; FOXO3_HUMAN; FOXO3A; MGC12739; MGC31925. |
| 产品应用 | WB=1:500-2000, IHC-P=1:50-200, IHC-F=1:50-200, IF=1:50-200 Not yet tested in other applications. |
| 交叉反应 | Human, Mouse, Rat |
| 抗体来源 | Rabbit |
| 免疫原 | A synthesized peptide derived from human FOXO3A around the phosphorylation site of S253 |
| 亚型 | IgG |
| 性状 | Liquid |
| 纯化方法 | affinity purified by Protein A |
| 克隆类型 | Recombinant |
| 理论分子量 | 71 kDa |
| 浓度 | 1mg/ml |
| 储存液 | 0.01M TBS (pH7.4) with 1% BSA, 0.02% Proclin300 and 50% Glycerol. |
| 研究领域 | Epigenetics and Nuclear Signaling > Transcription > Domain Families > Forkhead Box Epigenetics and Nuclear Signaling > Transcription > Domain Families > Forkhead Box > FOXO |
| 亚基 | Interacts with YWHAB/14-3-3-beta and YWHAZ/14-3-3-zeta, which are required for cytosolic sequestration. Upon oxidative stress, interacts with STK4/MST1, which disrupts interaction with YWHAB/14-3-3-beta and leads to nuclear translocation. Interacts with PIM1. |
| 亚细胞定位 | Cytoplasm, cytosol. Nucleus. Note=Translocates to the nucleus upon oxidative stress and in the absence of survival factors. Tissue Specificity : Ubiquitous. |
| 组织特异性 | Ubiquitous. |
| 翻译后修饰 | In the presence of survival factors such as IGF-1, phosphorylated on Thr-32 and Ser-253 by AKT1/PKB. This phosphorylated form then interacts with 14-3-3 proteins and is retained in the cytoplasm. Survival factor withdrawal induces dephosphorylation and promotes translocation to the nucleus where the dephosphorylated protein induces transcription of target genes and triggers apoptosis. Although AKT1/PKB doesn't appear to phosphorylate Ser-315 directly, it may activate other kinases that trigger phosphorylation at this residue. Phosphorylated by STK4/MST1 on Ser-209 upon oxidative stress, which leads to dissociation from YWHAB/14-3-3-beta and nuclear translocation. Phosphorylated by PIM1. Phosphorylation by AMPK leads to the activation of transcriptional activity without affecting subcellular localization. Phosphorylation by MAPKAPK5 promotes nuclear localization and DNA-binding, leading to induction of miR-34b and miR-34c expression, 2 post-transcriptional regulators of MYC that bind to the 3'UTR of MYC transcript and prevent its translation. |
| 相似性 | Contains 1 fork-head DNA-binding domain. |
| 功能 | Transcriptional activator which triggers apoptosis in the absence of survival factors, including neuronal cell death upon oxidative stress. Recognizes and binds to the DNA sequence 5'-[AG]TAAA[TC]A-3'. Participates in post-transcriptional regulation of MYC: following phosphorylation by MAPKAPK5, promotes induction of miR-34b and miR-34c expression, 2 post-transcriptional regulators of MYC that bind to the 3'UTR of MYC transcript and prevent its translation. |
| 保存条件 | Shipped at 4℃. Store at -20℃ for one year. Avoid repeated freeze/thaw cycles. |
| 注意事项 | This product as supplied is intended for research use only, not for use in human, therapeutic or diagnostic applications. |
| 背景资料 | This gene belongs to the forkhead family of transcription factors which are characterized by a distinct forkhead domain. This gene likely functions as a trigger for apoptosis through expression of genes necessary for cell death. Translocation of this gene with the MLL gene is associated with secondary acute leukemia. Alternatively spliced transcript variants encoding the same protein have been observed. [provided by RefSeq, Jul 2008] |
| 应用 | 推荐稀释比例 |
| {WB} | {1:500-2000} |
| {IHC-P} | {1:50-200} |
| {IHC-F} | {1:50-200} |
| {IF} | {1:50-200} |

25 ug total protein per lane of various lysates (see on figure) probed with Phospho-FoxO3a (Ser253) monoclonal antibody, unconjugated (bsm-52156R) at 1:1000 dilution and 4°C overnight incubation. Followed by conjugated secondary antibody incubation at r.t. for 60 min.

Paraformaldehyde-fixed, paraffin embedded Mouse Cerebrum; Antigen retrieval by boiling in sodium citrate buffer (pH6.0) for 15 min; The section was incubated with Phospho-FoxO3a (Ser253) Monoclonal Antibody, Unconjugated (bsm-52156R) at 1:200 overnight at 4°C, followed by conjugation to the bs-0295G-HRP and DAB (C-0010) staining.

Paraformaldehyde-fixed, paraffin embedded Rat Cerebrum; Antigen retrieval by boiling in sodium citrate buffer (pH6.0) for 15 min; The section was incubated with Phospho-FoxO3a (Ser253) Monoclonal Antibody, Unconjugated (bsm-52156R) at 1:200 overnight at 4°C, followed by conjugation to the bs-0295G-HRP and DAB (C-0010) staining.

Paraformaldehyde-fixed, paraffin embedded Human Cerebrum; Antigen retrieval by boiling in sodium citrate buffer (pH6.0) for 15 min; The section was incubated with Phospho-FoxO3a (Ser253) Monoclonal Antibody, Unconjugated (bsm-52156R) at 1:200 overnight at 4°C, followed by conjugation to the bs-0295G-HRP and DAB (C-0010) staining.

Paraformaldehyde-fixed, paraffin embedded Rat Liver; Antigen retrieval by boiling in sodium citrate buffer (pH6.0) for 15 min; The section was incubated with Phospho-FoxO3a (Ser253) Monoclonal Antibody, Unconjugated (bsm-52156R) at 1:200 overnight at 4°C, followed by conjugation to the bs-0295G-HRP and DAB (C-0010) staining.

Paraformaldehyde-fixed, paraffin embedded Human Tonsil; Antigen retrieval by boiling in sodium citrate buffer (pH6.0) for 15 min; The section was incubated with Phospho-FoxO3a (Ser253) Monoclonal Antibody, Unconjugated (bsm-52156R) at 1:200 overnight at 4°C, followed by conjugation to the bs-0295G-HRP and DAB (C-0010) staining.
Paraformaldehyde-fixed, paraffin embedded Human Pancreas; Antigen retrieval by boiling in sodium citrate buffer (pH6.0) for 15 min; The section was incubated with Phospho-FoxO3a (Ser253) Monoclonal Antibody, Unconjugated (bsm-52156R) at 1:200 overnight at 4°C, followed by conjugation to the bs-0295G-HRP and DAB (C-0010) staining.
风险提示:丁香通仅作为第三方平台,为商家信息发布提供平台空间。用户咨询产品时请注意保护个人信息及财产安全,合理判断,谨慎选购商品,商家和用户对交易行为负责。对于医疗器械类产品,请先查证核实企业经营资质和医疗器械产品注册证情况。
 文献和实验
文献和实验该产品被引用文献
[IF={{ 2.8 }}] {Jinghua Zhao. et al. The Effect of FSH-Induced Nuclear Exclusion of FOXO3/4 on Granulosa Cell Proliferation and Apoptosis of Hen Ovarian Follicles. GENES-BASEL. 2025 May;16(5):500} {WB} {Hen}
 技术资料
技术资料暂无技术资料 索取技术资料
文献支持
phospho-FoxO3a (Ser253) Recombinant Rabbit mAb(bsm-52156R)-50ul/100ul
¥1400 - 2500





